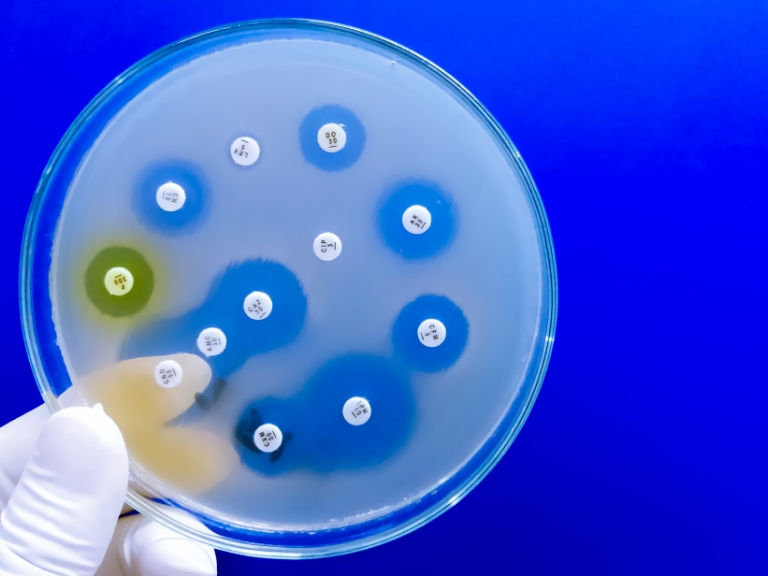
Übersicht zu Antibiotikaresistenz in Indien mit Berner Tool

Uni Bern Magazin: Thema Gesundheit und Medizin
Virenjagd, digitale Diagnostik, Tierwohl
Gesundheit und Medizin
Neuartige Viren, Bakterienresistenzen und der Fachkräftemangel in der Medizin stellen unsere Gesellschaft vor grosse Herausforderungen. Um diese anzugehen, entwickeln Forschende der Universität Bern preisgekrönte Werkzeuge und Methoden und betreiben innovative Nachwuchsförderung.